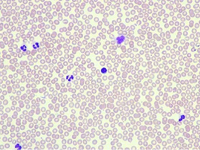
Blood Image of Iron Deficiency Anemia
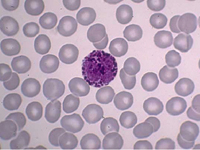
Blood Image of Basophils,a rare type of white cell
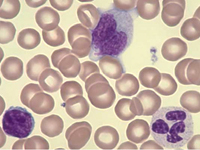
Blood Image of Virus affected lymphocytes
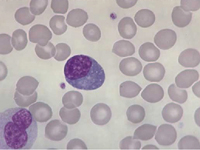
Rare type of blood cancer-Plasma cell leukemia

Photo Gallery
Photo Gallery

Related Pages
He has done over 10000 bone marrow procedures in the last 30 years and considered an expert in diagnostic hematology.
He is a member of the Indian and American Societies of Hematology.
You can consult your Doctor digitally through
email and WhatsApp


